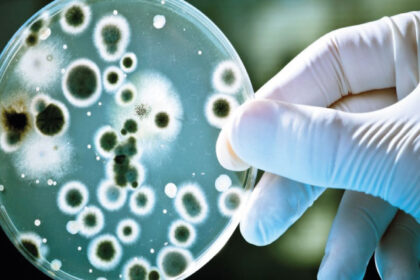

What Are The Benefits Of Yoga And Meditation?
Yoga and meditation are ancient and versatile practices used to improve physical…
Basic Things to Know About Mental Health:
Mental health relates to a range of factors that influence an individual's…
Virtual Reality: Psychological Depths and Interactions:
Virtual Reality: Psychological Depths and Interactions: These issues are important for understanding…
Non-Communicable Diseases: Definitions And Examples:
Non-Communicable Diseases: Definitions And Examples : Certainly! Non-communicable diseases (NCDs), also known…